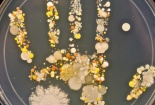
Các nhà khoa học đã phát minh ra 'Chất khử trùng Nano' trong hình dạng nước

Thương hiệu Hội nhập
Công nghệ

Đổi mới sáng tạo – động lực từ toàn dân đến quốc gia
(VietQ.vn) - Đổi mới sáng tạo ở Việt Nam không chỉ là nhiệm vụ của doanh nghiệp hay các nhà khoa học, mà đã trở thành phong trào toàn dân. Khi cả cộng đồng cùng chung tay, đổi mới sáng tạo được lan tỏa thành lối sống, mở ra động lực để đất nước bứt phá.
-
Các nhà khoa học đã phát minh ra 'Chất khử trùng Nano' trong hình dạng nước
Dạy và học từ xa tại nhà miễn phí qua hệ thống ViettelStudy.vn trong thời gian nghỉ tránh dịch Covid-19
Tìm ra phương pháp mới điều trị virus corona, tăng cơ hội cứu sống bệnh nhân nguy kịch
Xiaomi ra mắt máy phát hiện camera quay lén, giá 330.000 đồng
Công nghệ wifi không dây được triển khai thí điểm tại Thái Nguyên
Thế giới mất 8 tỷ USD 1 ngày vì ô nhiễm không khí
Viettel phản hồi thông tin của Facebook liên quan đến Công ty Mytel
-

Đổi mới sáng tạo: Từ 'bài toán khó' của đất nước thành 'cơ hội mới' cho tương lai
-

Nhiều bệnh viện lớn bị tấn công mạng, dữ liệu bệnh nhân bị rao bán trên diễn đàn hacker
Tin mới Công nghệ 24h

Công nghệ biến 1 hạt mưa thắp sáng 100 bóng đèn
(VietQ.vn) - Các nhà nghiên cứu đã phát triển một máy phát điện nhỏ giọt hoạt động dựa trên nguyên lý: Mỗi hạt mưa có thể tạo ra lượng điện 140 volt trong thời gian ngắn, tương đương đủ thắp sáng 100 bóng đèn bulb.

Chỉ trong 3 giờ, Mỹ phát triển thành công vaccine phòng virus corona
(VietQ.vn) - Công ty Dược phẩm Inovio (Mỹ) cho biết đang tiến hành các cuộc thử nghiệm tiền lâm sàng loại vaccine phòng virus corona chủng mới (Covid-19) được họ phát triển trong vòng 3 giờ.

MWC Barcelona 2020 có nguy cơ hủy bỏ vì dịch Corona
(VietQ.vn) - Vào thứ sáu tới (14/2) các nhà tổ chức MWC Barcelona 2020 sẽ gặp nhau để bàn bạc về tình hình và đưa ra kế hoạch dự phòng trước việc hàng loạt công ty lớn rút lui vì virus Corona.

Cập nhập Microsoft Windows Systems để vá 99 lỗi bảo mật mới
(VietQ.vn) - Microsoft vừa phát hành phiên bản cập nhập với các bản vá cho tổng số 99 lỗ hổng mới. Theo thông báo, 12 trong tổng số các vấn đề được vá là rất nghiêm trọng và 87 vấn đề còn lại được liệt kê là quan trọng.

Năm 2020, khởi nghiệp sáng tạo có thêm nhiều động lực để phát triển mạnh mẽ
(VietQ.vn) - Năm 2020, phong trào khởi nghiệp sáng tạo của Việt Nam được dự đoán sẽ tiếp tục phát triển mạnh mẽ khi có thêm nhiều dư địa, động lực mới.

Xuất hiện loại lốp xe thông minh kết nối mạng 5G giúp phương tiện an toàn khi lưu thông
(VietQ.vn) - Công nghệ lốp xe thông minh được trang bị cảm biến bên trong giúp người lái cảm thấy an toàn khi lưu thông và là bước tiến mới đối với phương tiện xe tự lái.

Chế tạo thành công thiết bị cầm tay phát hiện virus corona chỉ trong 'tích tắc'
(VietQ.vn) - Các nhà khoa học Trung Quốc vừa phát triển một thiết bị cầm tay có khả năng nhận diện những trường hợp nghi nhiễm virus corona (chủng mới Covid-19).

Máy tính bị đánh cắp dữ liệu thông qua độ sáng màn hình
(VietQ.vn) - Hacker có thể đánh cắp các dữ liệu nhạy cảm từ máy tính chỉ bằng thao tác thay đổi độ sáng của màn hình.

Chiêm ngưỡng vẻ đẹp của Galaxy Z Flip, giá khoảng 32 triệu đồng
(VietQ.vn) - Samsung chính thức công bố mẫu điện thoại màn hình gập thế hệ thứ hai của mình mang tên Galaxy Z Flip tại sự kiện Unpacked 2020.

Infographic: 12 bước để thực hiện GEMBA WALK hiệu quả
(VietQ.vn) - Gemba Walk là kỹ thuật quản lý ngày càng phổ biến. Bằng cách thực hiện các chuyến đi đến nơi làm việc, các nhà lãnh đạo có được cái nhìn sâu sắc vào dòng giá trị và thường khám phá ra các cơ hội cải tiến và tìm ra những cách thức mới để hỗ trợ nhân viên. Cách tiếp cận này là một phương pháp cộng tác, trong đó các nhân viên cung cấp thông tin chi tiết về những gì được thực hiện và lý do tại sao.

Sóng di động không ảnh hưởng sức khỏe?
(VietQ.vn) - Đây là câu trả lời từ phía Cục Quản lý thực phẩm và dược phẩm (FDA) Mỹ sau khi xem xét các nghiên cứu khoa học sau 11 năm vẫn tin chắc rằng sức khỏe sẽ không có bất kỳ rủi ro nào vì tiếp xúc với sóng điện thoại di động.

Nữ tiến sĩ Việt chế tạo thành công pin nhiên liệu đặc biệt, rẻ hơn bình thường 60 triệu đồng
(VietQ.vn) - Công trình của nhóm nghiên cứu của PGS.TS Hồ Thị Thanh Vân cùng nhóm sinh viên Trường ĐH Bách khoa (ĐH Quốc gia TP.HCM) góp phần giảm lượng kim loại quý dùng trong pin nhiên liệu, giảm giá thành pin so với bình thường khoảng 60 triệu đồng.

Xuất hiện kính hiển vi cực nhanh để nghiên cứu lượng tử, theo dõi electron của nguyên tử đơn
(VietQ.vn) - Các nhà nghiên cứu từ Viện Max Planck ở Đức đã chế tạo được chiếc kính hiển vi cực nhanh có thể sử dụng trong nghiên cứu lượng tử, đồng thời còn theo dõi các electron của nguyên tử đơn.

Công nghệ độc đáo: In 3D trực tiếp tế bào lên vết thương để điều trị bỏng
(VietQ.vn) - Các nhà khoa học Canada vừa sử dụng máy in 3D để in trực tiếp các tế bào da mới lên vết thương do bỏng. Phương pháp này sẽ đẩy nhanh quá trình điều trị cho những bệnh nhân bị tổn thương da nghiêm trọng.

Bản cập nhật liên tục mắc lỗi của Windows 10 khiến người dùng ngán ngẩm
(VietQ.vn) - Tính đến thời điểm hiện tại, Windows 10 được coi là hệ điều hành khá tốt, nhưng nó cũng mang tới cho người dùng rất nhiều sự khó chịu từ những lỗi sau cập nhật của mình.

Viettel đẩy mạnh phổ cập 4G tại Việt Nam
(VietQ.vn) - Viettel sẽ phối hợp với các nhà cung cấp bán điện thoại 4G giá 400.000 đồng để đẩy mạnh phổ cập 4G. Mục tiêu của Viettel là có thêm 10 triệu thuê bao 4G tại Việt Nam, tăng tỷ lệ từ 43,5% lên 62% trong năm 2020.

Bắt đầu thử nghiệm thuốc điều trị virus corona tại Việt Nam
(VietQ.vn) - Bộ trưởng Bộ Khoa học và công nghệ Chu Ngọc Anh vừa phê duyệt bổ sung đề tài độc lập cấp nhà nước 'Đánh giá hiệu quả và tính an toàn của việc bổ sung lopinavir/ritonavir phối hợp trong điều trị người bệnh nhiễm virus corona mới'.

Ứng dụng đặc biệt giúp người dùng kiểm tra mức độ tiếp xúc với nguồn lây nhiễm virus corona
(VietQ.vn) - Trung Quốc vừa phát triển thành công ứng dụng di động cho phép phát hiện các trường hợp có khả năng lây nhiễm virus corona chủng mới (2019-nCoV) khi có 'tiếp xúc gần'

Kỳ lạ thiết bị thông minh có khả năng phân biệt giày thật, giày giả trong 1 phút
(VietQ.vn) - Công ty Entrupy vừa cho ra mắt thiết bị thông minh Legit Check Tech có khả năng phát hiện, phân biệt giày thật và giày giả chỉ trong vòng một phút.

Hành trình 'thần tốc' tạo ra bộ kit test nhanh virus corona 'made in Vietnam'
(VietQ.vn) - Chỉ trong vòng chưa đầy một tháng, nhóm nghiên cứu của TS. Lê Quang Hòa, Viện Công nghệ sinh học và công nghệ thực phẩm (Đại học Bách khoa Hà Nội) đã chế tạo thành công bộ kit test nhanh virus corona cho kết quả trong vòng 70 phút.





